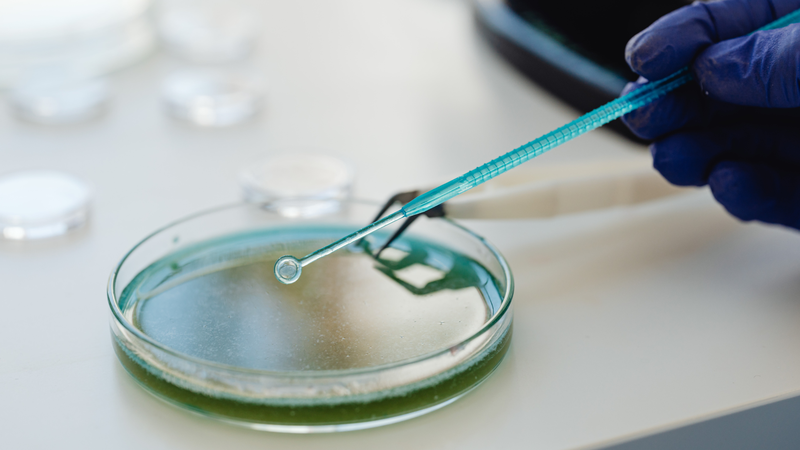
Cắt bao quy đầu ở nam giới có thể bảo vệ chống lại nhiễm HPV ở cả nam và nữ 3

Từng làm ở Viện ISDS, nhiều năm cộng tác với CDC Thái Nguyên triển khai dự án phòng chống HIV/AIDS, 2 năm cộng tác với WHO.
Kim Toàn
29/10/2024
Mặc định
Lớn hơn
Cắt bao quy đầu là một thủ thuật phẫu thuật phổ biến, được thực hiện cho nhiều lý do khác nhau. Gần đây, có nghiên cứu đã chỉ ra rằng việc cắt bao quy đầu không chỉ có lợi cho nam giới mà còn có tác dụng bảo vệ người nữ khỏi nhiễm virus Papilloma ở người (HPV). Theo dõi bài viết dưới đây để biết thêm thông tin chi tiết về vấn đề cắt bao quy đầu ở nam giới có thể bảo vệ, chống lại nhiễm HPV ở cả nam và nữ.
Một nghiên cứu tổng hợp được công bố trên Tạp chí Vi sinh học và Nhiễm trùng Lâm sàng đã phân tích tác dụng bảo vệ của việc cắt bao quy đầu ở nam giới đối với việc giảm nguy cơ nhiễm virus HPV. Kết quả cho thấy, cắt bao quy đầu giúp giảm tỷ lệ lây nhiễm HPV ở nam giới và giảm nguy cơ nhiễm HPV cho bạn tình nữ của họ. Điều này có thể góp phần làm giảm tỷ lệ mắc các bệnh liên quan đến HPV, nhấn mạnh vai trò tiềm năng của cắt bao quy đầu trong việc ngăn ngừa nhiễm HPV.
Virus Papilloma ở người (HPV) là bệnh lây truyền qua đường tình dục phổ biến nhất trên toàn thế giới. HPV có nhiều loại, trong đó các loại HPV nguy cơ thấp thường gây ra mụn cóc sinh dục, còn các loại nguy cơ cao có thể dẫn đến ung thư cổ tử cung. Do vậy, phòng ngừa nhiễm HPV đóng vai trò quan trọng trong việc bảo vệ sức khỏe tình dục và giảm nguy cơ ung thư.

Việc cắt bao quy đầu ở nam giới được cho là giúp ngăn ngừa nhiều bệnh lây truyền qua đường tình dục cũng như các tình trạng liên quan đến hoạt động tình dục.
Các nghiên cứu chỉ ra rằng cắt bao quy đầu giúp giảm nguy cơ mắc các bệnh như HIV, virus Herpes simplex loại 2, giang mai, loét sinh dục, hạ cam và nhiễm nấm Candida. Điều này cho thấy lợi ích của việc cắt bao quy đầu không chỉ nằm ở giảm nguy cơ nhiễm HPV mà còn ở nhiều bệnh khác.
Bài tổng quan có hệ thống đã đánh giá tác dụng bảo vệ của cắt bao quy đầu đối với nguy cơ nhiễm HPV ở nam giới và bạn tình nữ của họ. Các nhà khoa học đã phân tích dữ liệu từ nhiều nghiên cứu khác nhau và xem xét sự khác biệt về tác dụng bảo vệ của cắt bao quy đầu tùy theo các vị trí khác nhau trên dương vật. Điều này giúp cung cấp cái nhìn toàn diện hơn về lợi ích của cắt bao quy đầu trong việc ngăn ngừa nhiễm HPV và các bệnh tình dục khác.
Trong nghiên cứu này, các nhà khoa học đã tìm kiếm nhiều cơ sở dữ liệu khoa học để thu thập các nghiên cứu quan sát và thực nghiệm. Họ chọn ra những nghiên cứu báo cáo về tác động của việc cắt bao quy đầu đối với tỷ lệ hiện mắc bệnh, tỷ lệ mới mắc bệnh, khả năng loại bỏ nhiễm HPV ở nam giới và bạn tình nữ của họ.

Về mặt khái niệm, tỷ lệ hiện mắc bệnh nhiễm trùng HPV phản ánh sự hiện diện của nhiễm HPV tại bất kỳ thời điểm nào trong nhóm đối tượng nghiên cứu. Tỷ lệ mới mắc đề cập đến các trường hợp nhiễm HPV mới phát sinh, tức là những trường hợp chưa từng nhiễm trước đó. Khả năng thanh thải nhiễm trùng là khả năng tự loại bỏ virus HPV khỏi cơ thể, tức là sự vắng mặt của nhiễm trùng HPV đã từng tồn tại trước đó.
Các khái niệm này giúp nhóm nghiên cứu đánh giá toàn diện các khía cạnh của việc cắt bao quy đầu trong ngăn ngừa và làm giảm nguy cơ nhiễm HPV.
Ban đầu, các nhà khoa học đã sàng lọc 1.409 nghiên cứu trong đó có 32 nghiên cứu (bao gồm 25 nhóm quần thể nghiên cứu khác nhau) được đưa vào để phân tích và đánh giá có hệ thống, với các nghiên cứu này được công bố trong khoảng thời gian từ năm 2002 đến năm 2022.
Trong số các nghiên cứu đã chọn, có 17 nghiên cứu cắt ngang, 10 nghiên cứu so sánh hai nhóm theo phương pháp cắt ngang và 5 nghiên cứu là thử nghiệm lâm sàng ngẫu nhiên. Các loại nghiên cứu này cung cấp một cái nhìn đa dạng về tác động của việc cắt bao quy đầu trong việc phòng ngừa nhiễm HPV.
Để phát hiện nhiễm HPV và phân tích kiểu gen, các mẫu được thu thập từ nhiều vị trí khác nhau trên cơ thể nam giới, bao gồm niệu đạo, bao quy đầu, quy đầu hoặc rãnh, thân dương vật, bìu và vùng quanh hậu môn. Ở nữ giới, mẫu được thu thập từ cổ tử cung và âm đạo. Điều này cho phép đánh giá cụ thể hơn về mối liên quan giữa vị trí nhiễm HPV và hiệu quả phòng ngừa của việc cắt bao quy đầu.
Tỷ lệ nhiễm HPV ở tất cả những người tham gia nghiên cứu ban đầu dao động từ 8,7% đến 69,8%. Trong số đó, 21 nghiên cứu đã báo cáo mối liên quan giữa việc cắt bao quy đầu và tỷ lệ nhiễm HPV ở nam giới.
Theo ước tính từ các nghiên cứu này, việc cắt bao quy đầu giúp giảm đáng kể nguy cơ nhiễm HPV, đặc biệt là ở quy đầu và thân dương vật. Hiệu quả bảo vệ cao nhất của cắt bao quy đầu được ghi nhận ở quy đầu, không phân biệt loại virus, cho dù là loại HPV nguy cơ thấp hay nguy cơ cao.
Ngoài ra, mối liên quan giữa cắt bao quy đầu và tỷ lệ nhiễm HPV ở nam giới đã được xác nhận bởi 9 nghiên cứu. Kết quả cho thấy rằng cắt bao quy đầu làm giảm rõ rệt nguy cơ nhiễm HPV tại quy đầu, và điều này vẫn đúng ngay cả khi phân tích theo các loại HPV khác nhau, cho thấy tác động tích cực của cắt bao quy đầu trong việc bảo vệ chống lại nhiễm HPV.
Mối liên quan giữa việc cắt bao quy đầu và khả năng loại bỏ nhiễm HPV ở nam giới đã được 7 nghiên cứu ghi nhận. Các nghiên cứu này cho thấy rằng cắt bao quy đầu không chỉ giúp giảm nguy cơ nhiễm HPV mà còn làm tăng đáng kể tỷ lệ loại bỏ nhiễm trùng HPV tại quy đầu.
Điều đáng chú ý là hiệu quả này xảy ra không phụ thuộc vào loại HPV, cho dù là các loại nguy cơ thấp hay nguy cơ cao. Điều này cho thấy rằng cắt bao quy đầu có thể đóng vai trò quan trọng trong việc giúp cơ thể tự loại bỏ virus HPV, từ đó giảm nguy cơ mắc các bệnh liên quan đến HPV.

Tổng cộng có 6 nghiên cứu điều tra mối liên hệ giữa cắt bao quy đầu ở nam giới và kết quả nhiễm HPV ở bạn tình nữ của nam giới đã cắt bao quy đầu. Trong các nghiên cứu này, việc cắt bao quy đầu đã giảm đáng kể nguy cơ nhiễm HPV nguy cơ cao và tỷ lệ mới nhiễm HPV nguy cơ cao ở bạn tình nữ.
Bên cạnh đó, một kết quả tương tự nhưng không rõ ràng cũng được ghi nhận đối với các bệnh nhiễm trùng phổ biến và nhiễm HPV nguy cơ thấp. Mặc dù mức độ giảm nguy cơ này không mạnh mẽ như đối với HPV nguy cơ cao, nhưng vẫn cho thấy rằng cắt bao quy đầu có thể có tác động tích cực đến sức khỏe tình dục của bạn tình nữ. Kết quả này nhấn mạnh vai trò quan trọng của cắt bao quy đầu trong việc bảo vệ không chỉ cho nam giới mà còn cho bạn tình nữ khỏi nguy cơ nhiễm HPV.
Tổng quan nghiên cứu này cho thấy rằng việc cắt bao quy đầu ở nam giới có tác dụng bảo vệ rõ rệt đối với tỷ lệ mắc và khả năng loại bỏ nhiễm trùng HPV ở quy đầu dương vật.
Ngoài ra, cắt bao quy đầu cũng giúp bảo vệ bạn tình nữ của nam giới đã cắt bao quy đầu khỏi nguy cơ mắc bệnh HPV.
Như đã đề cập trong bài viết, cắt bao quy đầu được cho là có tác dụng bảo vệ chống lại các bệnh lây truyền qua đường tình dục bằng cách thay đổi quá trình sừng hóa và môi trường miễn dịch tại chỗ của dương vật.
Tổng quan nghiên cứu cho thấy rằng cắt bao quy đầu ở nam giới có thể là một biện pháp phòng ngừa tiềm năng, đặc biệt tại những khu vực mà ung thư liên quan đến HPV phổ biến và chưa có tiêm vắc xin phòng ngừa HPV.

Như vậy, không chỉ là một phương pháp can thiệp phẫu thuật đơn thuần, cắt bao quy đầu ở nam giới có thể bảo vệ chống lại nhiễm HPV ở cả nam và nữ. Cảm ơn bạn đọc đã theo dõi bài viết, đừng quên nhấn theo dõi website Nhà thuốc Long Châu để cập nhật những thông tin sức khỏe mới nhất và sớm nhất nhé!
Dược sĩ Đại học Nguyễn Tuấn Trịnh
Từng làm ở Viện ISDS, nhiều năm cộng tác với CDC Thái Nguyên triển khai dự án phòng chống HIV/AIDS, 2 năm cộng tác với WHO.